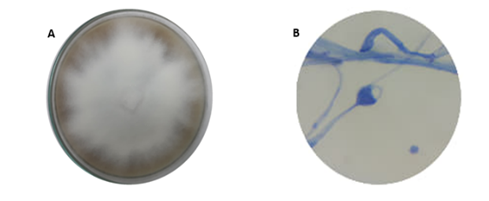
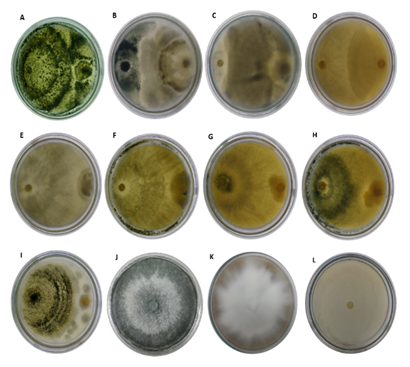

INTRODUCCIÓN
El aguacate es considerado uno de los principales cultivos en zonas tropicales y subtropicales del mundo. Esta fruta ha presentado una gran demanda en los mercados nacionales e internacionales debido a su alto contenido nutricional, aplicación en la industria cosmética y farmacéutica (Araújo et al., 2018), lo que ha provocado el interés en países que tienen zonas con suelos ricos en minerales y fuentes hídricas adecuadas para su producción (Ramirez et al., 2018). En los últimos años, la producción mundial de aguacate fue de aproximadamente de 4,2 millones de toneladas por año, siendo Colombia el cuarto productor de aguacate del mundo, aportando el 5 % de la producción mundial de este fruto (Arias y Moors, 2018). En Colombia, los departamentos que presentan mayor producción de aguacate son Caldas, Antioquia, Bolívar, Cauca, Risaralda, Quindío y Tolima, éste último, el de mayor producción aportando aproximadamente 84.341 ton (Ministerio de Agricultura y Desarrollo Rural, MADR, 2019).
Una de las principales actividades económicas de los Montes de María, específicamente de los municipios de Ovejas y Chalán, es la producción del cultivo de aguacate, que junto al municipio del Carmen de Bolívar y San Jacinto representan el 90 % del total de la producción regional (Aguilera, 2013; Osorio, 2017), sin embargo, en los últimos años el cultivo de aguacate en los Montes de María ha presentado problemas fitosanitarios, que pudieron ocurrir por el abandono de los agricultores de sus parcelas por causa del conflicto armado en la zona (Burbano, 2019), lo que favoreció la proliferación de enfermedades por la falta de control fitosanitario. Dentro de las enfermedades que actualmente afectan el cultivo de aguacate en los Montes de María se encuentra la tristeza del aguacate o pudrición radicular ocasionado por Phytophthora cinnamomi, la cual ha disminuido de manera considerable la producción y comercialización del fruto en la subregión (Puello, 2016; Hardhman and Blackman, 2018).
La enfermedad en la planta de aguacate se caracteriza por presentar lesiones necróticas en el sistema radicular ocasionando una disminución en la absorción de agua y minerales (Mamani, 2017; Sena et al., 2019). A medida que la infección avanza, se observa la base del tallo necrosa lo que provoca que las ramas principales y secundarias comiencen a secarse y el fruto no se desarrolle por completo (Masikane et al., 2019).
Actualmente, el control de la enfermedad se basa principalmente en la aplicación de productos químicos como las sales de fosfito y metalaxis, que bloquean el desarrollo de P. cinnamomi, sin embargo, estos agroquímicos ocasionan cambios en la microbiota del suelo, degradación del suelo y eutrofización. Así mismo, ha generado que cepas se vuelvan resistentes a los fungicidas comerciales y, a su vez, estos afectan el ambiente y la salud, por lo que es necesario la búsqueda de nuevos agentes antifúngicos de bajo impacto ecológico (Olea et al., 2019; Belisle et al., 2019).
Una alternativa para sustituir el control químico es el género Trichoderma, que incluye diversas especies de importancia agrícola para el control biológico y la promoción de crecimiento vegetal (Nawaz et al., 2018). Trichoderma spp. tienen la capacidad de sintetizar una gran diversidad de moléculas como biocontrol contra fitopatógenos e inducir en la planta mecanismos moleculares como la resistencia sistémica adquirida (SAR) y resistencia sistémica inducida (ISR) (Saravanakumar et al., 2018; Baiyee et al., 2019). Además de ser una herramienta biotecnológica porque presentan grandes beneficios para la agricultura, como inductores de la actividad promotora de crecimiento vegetal, la producción de enzimas y metabolitos que ayudan a inhibir los patógenos que ocasionan enfermedades en plantas (Ye et al., 2020; Zin and Badaluddin, 2020; Manzar et al., 2020; Macías et al., 2020).
Dada la importancia biológica de las especies de Trichoderma spp., en la actualidad ha aumentado el interés por descubrir nuevas especies en diferente hábitat, sin embargo, en el departamento de Sucre no se han realizado estudios previos que utilicen cepas nativas de Trichoderma spp. como alternativa biológica para el manejo del fitopatógeno P. cinnamomi en plantaciones de aguacate. Por tal razón, el presente estudio tuvo como objetivo evaluar la actividad inhibitoria in vitro de cepas nativas de Trichoderma spp. contra P. cinnamomi aisladas de cultivares de aguacate de los Montes de María, departamento de Sucre.
MÉTODO
Área de estudio
La investigación se realizó en los municipios de Ovejas (9°31′33″N 75°13′38″O y altitud de 254 m.s.n.m) y Chalán (9°32′38″N 75°18′45″O y altitud de 270 m.s.n.m), pertenecientes a la subregión Montes de María, departamento de Sucre, Colombia, clasificada como zona de bosque seco tropical con paisaje característico de montaña. Presenta una temperatura promedio de 27 °C y con precipitaciones que pueden variar entre los 1,000 y 1,200 mL al año (Aguilera, 2013; Martínez et al., 2016).
Aislamiento de Phytophthora cinnamomi
Se recolectaron raíces de plantas de aguacate con síntomas característicos de ataque de P. cinnamomi Rands. Las muestras de las raíces recolectadas fueron lavadas con agua destilada estéril, luego se realizaron cortes de 2 cm para ser sometidos a desinfección superficial con etanol (70 %) por 30 s, seguido de un lavado en agua destilada estéril por 30 s, después sumergidas en hipoclorito de sodio (3 %) por 30 s y, por último, se lavaron con agua destilada estéril por 30 s. De las muestras desinfestadas se cortaron trozos pequeños de 1 mm y se sembraron en medio V8 (jugo V8 200 mL, CaCO3 3,0 g, agar 15,0 g, pH: 6,5 en 1,000 mL de agua destilada) (Mamani, 2017). Las cajas Petri inoculadas se incubaron a 28 ºC por 15 días (Chañag et al., 2018).
Cultivos trampa para la captura de Trichoderma spp
Los muestreos se realizaron en la unidad productiva de cultivos de aguacate en los municipios de Chalán (Vereda el Limón) y Ovejas (Vereda Salitral), para ello se utilizaron cultivos trampas construidas con recipientes plásticos, en los cuales fueron colocadas porciones de arroz precocido, luego se cubrieron con una malla de gasa. Estas trampas fueron ubicadas por debajo del nivel del suelo al lado de las plantas de aguacate de forma aleatoria, por todo el lote de cultivo, se seleccionaron aquellos lugares con mayor humedad y presencia de materia orgánica en descomposición. En total se ubicaron 10 trampas por sitio de muestreo, las cuales se dejaron por un periodo de 7 a 14 días para darle tiempo al hongo de colonizar el arroz. Para garantizar el aislado de la cepa nativa se tomaron muestras de suelo, las cuales fueron recolectadas de 10 sitios o parcelas de cultivos de aguacate en el municipio de Chalán y Ovejas, donde no existían indicios de la aplicación de productos microbiológicos comerciales a base de Trichoderma. Por cada zona se tomaron 3 muestras de suelo (1 kg cada una), a una profundidad de 20 cm al lado de cada árbol de aguacate, se recolectaron con ayuda de una pala desinfectada previamente. Las muestras se depositaron en bolsas marca Ziploc debidamente selladas para luego ser transportadas al laboratorio de microbiología de la Universidad de Sucre para ser procesadas (Acurio y España, 2017; Nugra, 2018).
Identificación de los microorganismos aislados
Las cajas Petri que presentaron las características similares de Trichoderma spp. fueron asiladas a partir de los cultivos puros mediante la técnica de cinta adhesiva, la cual consiste en colocar la cinta sobre la superficie de la colonia de Trichoderma spp. y retirarla para posteriormente colocarla sobre un portaobjeto con una gota de lactofenol y observar al microscopio 4X a 40X. De cada aislamiento se observaron las estructuras macroscópicas (densidad del micelio, olor y color) y microscópicas (conidióforos, conidios, fiálide y forma de clamidósporas). La identificación taxonómica a nivel de género se realizó mediante las claves propuesta por Barnett y Hunter (1998), mientras que para la identificación de la especie de Phytophthora sp. se utilizó la guía de reconocimiento propuesta por (Tenorio, 2010).
Prueba in vitro de antagonismo de Trichoderma spp. contra Phytophthora cinnamomi
Se tomaron discos de micelio de aproximadamente 5 mm de diámetro de antagonista y patógeno, y se inocularon en ambos extremos en cajas Petri que contenían medio dual PDA-V8, separados aproximadamente 6 cm uno de otro; se incubaron a 28±2 C durante 12 días. Se utilizó como control negativo P. cinnamomi sin agroquímico y para el control positivo se aplicó 20 µL del fungicida fosetil aluminio. Los resultados de actividad inhibitoria se evidenciaron mediante el crecimiento de Trichoderma spp. en caja Petri (Martinez et al., 2008; De Oliveira et al., 2020; Rajani et al., 2020).
Para evaluar la capacidad antagónica de las cepas de Trichoderma spp. contra P. cinnamomi, se calculó el porcentaje de inhibición empleando la siguiente fórmula propuesta por Jaramillo (2014):
Donde R1 es el radio del patógeno testigo y R2 es el crecimiento radial del fitopatógeno expuesto al antagonista.
Así mismo, se utilizó la escala de antagonismo propuesta por Ezziyyani et al., (2005), con el fin de determinar el grado de actividad antagónica in vitro de Trichoderma spp. contra P. cinnamomi (cuadro 1).
Extracción de DNA de cepas de Trichoderma spp.
Del medio papa dextrosa-agar PDA (extracto de papa 4,0 g, dextrosa 20 g, agar-agar 15,0 g, pH: 6,5 en 1,000 mL de agua destilada) se extrajeron colonias puras de cada cepa de Trichoderma spp. y se incubaron a 25±2 °C por tres días con fotoperiodo (12 h luz/oscuridad). Se pesaron 100 mg de micelio fresco el cual fue macerado en nitrógeno líquido con la ayuda de un mortero. El DNA se extrajo con el kit comercial DNeasy Plant Mini® siguiendo el protocolo del fabricante (Vázquez et al., 2015; Gamarra et al., 2018). Para verificar la presencia de DNA fue realizada una electroforesis en gel de agarosa 0,5 % en tampón TBE; se tomaron 3 µL de DNA puro y se mezclaron con 4 µL de colorante Orange, usando como referencia un marcador molecular de 100 pb. Para la visualización con un tiempo de corrida de 2 horas a 70 voltios usando una fuente de poder Power PacTM Basic 300V/400mA/75W BIO-RAD.
Amplificación del gen factor de elongación de la traducción 1 (tef1)
El DNA extraído fue sometido a la reacción en cadena de la polimerasa (PCR) para amplificar la región del gen tef1 del DNAr. En la reacción de PCR se utilizó un volumen final de 25 µL de la mezcla de reacción, preparada de la siguiente manera: 2,5 µL de buffer; 1,5 μL de MgCl2 25 mM; 1,5 μL de dNTP 10 mM; 0,75 μL de iniciador EF1-728F5’-CATCGAGAAGTTCGAGAAGG-3’a 0,2 mM y 0,75 μL a 0,2 mM Tef1-Llevrev 5’-AACTTGCAGGCAA-TGTGG-3’; y 0,5 μL Taq DNA polimerasa en 12,5 μL de agua ultrapura estéril (Druzhinina, 2009; Maniscalco y Dorta, 2015). Se utilizó como control positivo Trichoderma harzianum y control negativo agua estéril.
Secuenciación de los productos de PCR
Los productos amplificados fueron enviados a secuenciación a la empresa Macrogen (Seoul, South Korea) en un secuenciador automático con capilar 3730XL. Las entidades de las secuencias nucleotídicas obtenidas fueron comparadas con las almacenadas en bancos de datos de la National Center for Biotechnology Information (NCBI). El alineamiento de las bases fue realizado por clustal W, las inferencias filogenéticas fueron obtenidas por método Neighbor-Joining basado en el modelo kimura-2-parámetro con prueba bootstrap 1.000 réplicas con el programa MEGA X.
Análisis estadístico
Se aplicó un diseño completamente al azar (DCA) para la actividad inhibitoria de Trichoderma spp. contra P. cinnamomi. Así mismo, se aplicó la prueba múltiple de rango Duncan para establecer diferencias (p<0,05) en cuanto a los porcentajes de inhibición de las cepas de Trichoderma spp. contra el fitopatógeno. El experimento se realizó por triplicado y los datos fueron analizados en el programa estadístico Infostat versión estudiantil.
RESULTADOS
Aislamiento de Trichoderma spp. y P. cinnamomi de cultivos de aguacate de los Montes de María
Fueron aisladas un total de 30 cepas (19 para el municipio de Chalán y 11 para el municipio de Ovejas). Debido a su crecimiento en medio PDA y observado sus estructuras bajo microscopio se pudo evidenciar que pertenecían al género Trichoderma (figura 1).

Figura 1 Estructura morfológica de Trichoderma spp. observada bajo microscopio óptico a 40X Municipio de (A) Ovejas y (B) Chalán. (a) conidióforos, (b) conidios.
P. cinnamomi se caracteriza por presentar un micelio algodonoso cuando crece en medio V8. Bajo microscopio, las hifas se observaron con hinchazones bien marcados, micelio sin septos y esporangio ovoide, las cuales son características particulares para identificar este tipo de microorganismo (figura 2).
Figura 2 Identificación microscópica de Phytophthora cinnamomi. (A) Crecimiento micelial (B) Esporangio ovoide 40X.
Actividad inhibitoria in vitro de Trichoderma spp. contra P. cinnamomi
De las 30 cepas de Trichoderma spp. aisladas de cultivos de aguacate en los municipios de Chalán y Ovejas, solo 5 cepas de Chalán y 4 de Ovejas presentaron inhibición contra patógeno (figura 3).
(A) C1OVLIM, (B) C2OVLIM, (C) C3OVLIM, (D) C4OVLIM, (E) C1CHLIM, (F) C2CHLIM, (G) C3CHLIM, (H) C4CHLIM, (I) C5CHLIM, (J) control negativo Trichoderma spp. (K) control negativo P. cinnamomi (L) control positivo P. cinnamomi + fosetil aluminio, (C): cepa, (OV): Ovejas, (CH): Chalán, (LIM): Laboratorio de Investigaciones Microbiológicas, Universidad de Sucre.
La prueba múltiple de rango Duncan muestra diferencias estadísticas significativas (p<0,05) entre las cepas aisladas de los municipios de Chalán y Ovejas, demostrando que las cepas C1OVLIM (94,5 %) y C5CHLIM (87,8 %) presentaron los mejores promedios de inhibición, mientras que el control químico (fosetil aluminio) el mayor promedio (98,6 %) de inhibición contra P. cinnamomi (figura 4).
El grado de actividad antagónica fue por micoparasitismo, la cepa C1OVLIMB fue de grado 5 ocupando completamente la superficie del medio de cultivo en presencia del patógeno, mientras que la cepa C5CHLIMB presentó grado 3 ocupando el 50% de la superficie del medio de cultivo en presencia del patógeno
Identificación molecular de Trichoderma spp.
El resultado obtenido a partir del análisis de las secuencias demostró que las cepas C1OVLIMB, C3OVLIMB, C4OVLIMB, C3CHLIMB, C2CHLIMB fueron identificadas como Trichoderma harzianum, mientras que C1CHLIMB, C5CHLIMB, C4 CHLIMB, C2OVLIMB, C4OVLIMB fueron identificadas como Trichoderma viride con un producto esperado de 1200 pb (figura 6).

Figura 6 Dendograma a partir de las secuencias del gen tef1 de Trichoderma spp. vereda Salitral, municipio de Ovejas (OV), vereda el Limón, municipio de Chalán (CH) departamento de Sucre.
Los caracteres taxonómicos juegan un papel importante al momento de identificar las especies de Trichoderma, pero muchas veces esta identificación puede ser subjetiva y muy dificultosa, ya que caracteres como conidios y conidióforos entre otros, son muy parecidos entre las especies, lo que ha ocasionado que haya un bajo número de especies identificadas morfológicamente en comparación a las que han sido identificadas filogenéticamente a partir de secuencias de DNA. Así mismo, el análisis morfológico es muy propenso a cometer errores y como consecuencia se podrían tener cepas de Trichoderma spp. mal identificadas en colecciones de cultivos de microorganismos (Umaña et al., 2019; Filizola et al., 2019; Sood et al., 2020).
Las herramientas moleculares se han convertido en una alternativa más precisa para la identificación de especies. Gracias a primers específicos se pueden diferenciar especies que son aisladas de diferentes ecosistemas, sin embargo, hay primers que son más específicos que otros. Diversos estudios han utilizado primers específicos para la región ITS1 e ITS2 pero estas regiones han presentado inconvenientes para identificar especies de Trichoderma, incluso pueden dar lugar a varios resultados de identificación para un mismo aislado, por tal razón el gen tef1 se caracteriza por ser una región por presentar una alta variabilidad intraespecífica (Maniscalco y Dorta, 2015; García et al., 2018; Fanelli et al., 2018).
Muchas de las especies de Trichoderma tienen una gran versatilidad al momento de competir por espacio, nutrientes, producción de metabolitos secundarios y micoparasitismo (Inglis et al., 2020; Kredics et al., 2018). Lo expuesto anteriormente es confirmado por Sánchez et al. (2019) donde demuestran que diferentes especies de Trichoderma presentaron inhibición contra Phytophthora rosacearum, P. inundata, P. lacustris, P. cactorum: en todos los casos se observó bajo microscopio electrónico el enrollamiento de Trichoderma spp.
Los resultados obtenidos en este estudio concuerdan con varias investigaciones que demuestran la inhibición mediante micoparasitismo de T. harzianum y T. viride contra diferentes especies de Phytophthora (Ezziyyani et al., 2005; Kredics et al., 2018; Belisle et al., 2019). Por ejemplo, en un estudio realizado por Braun et al., (2018) acerca del proceso de inhibición de T. harzianum contra hongos generadores de micotoxinas, demostró que esta especie puede actuar como micoparásito y liberar enzimas hidrolíticas como quitinasas y lacasas que tienen la capacidad de poder desintegrar la pared celular del patógeno, indicando que esta especie es considerada un buen control biológico in vitro. Así mismo, Kuzmanovska et al. (2018) evaluaron las especies de Trichoderma asperellum y T. harzianum contra Botrytis cinerea, uno de los principales patógenos que ataca al cultivo de tomate. Los resultados demostraron que T. harzianum y T. asperellum presentaron inhibición contra patógeno in vitro, tanto micelial como germinación conidial, demostrando que estas dos especies son agentes de control biológico para el control de la enfermedad del moho gris en el tomate.
El-Sharkawy et al., (2018) realizaron una combinación de micorrizas arbusculares con T. harzianum y T. viride con el fin de controlar la enfermedad de la roya del tallo en plantas de trigo ocasionado por Puccinia graminis. Los resultados obtenidos confirmaron que en condiciones de invernadero la combinación de micorrizas arbusculares con las dos especies de Trichoderma redujo la enfermedad, e indujo la producción de las enzimas peroxidasas y polifenol oxidasa y, a su vez, aumentó el contenido total de fenol y mejoró los parámetros de crecimiento.
T. viride ha demostrado ser un hongo con la capacidad de ejercer actividad inhibitoria contra P. cinnamomi (Hoyos et al., 2019; Abdel et al., 2019; Shafique et al., 2019) debido a que tienen la capacidad de inducir la producción de enzimas específicas como polifenol oxidasa, quitinasas y glucanasas en plántulas de maní que se encuentran infectadas contra Aspergillus niger (Gajera et al., 2015). Así mismo, Andrade-Hoyos et al. (2019) determinaron el potencial antagónico in vitro de Trichoderma harzianum, T. asperellum y T. viride provenientes de la rizosfera de aguacate contra Rhizoctonia solani, Fusarium oxysporum y Phytophthora capsici. Los resultaron confirmaron que las especies de Trichoderma spp. fueron eficiente para controlar el crecimiento de los patógenos in vitro. De igual forma, Nawaz et al. (2018) afirman que la aplicación de Trichoderma viride y T. harzianum mostraron una inhibición 85,5 % del crecimiento micelial de P. capsici, mientras que en condiciones de invernadero ambas especies de Trichoderma suprimieron significativamente la severidad de la podredumbre de la raíz, lo que favoreció el crecimiento del sistema radicular y biomasa vegetal.
Por otra parte, la inoculación de T. viride en plántulas de menta tuvo la capacidad de colonizar con mayor rapidez el sistema radicular de planta con el fin de promover su crecimiento, induciendo además una alta concentración de aceites esenciales en comparación con las plántulas sin inocular (Velmourougane et al., 2019; Guo et al., 2020; He et al., 2020; Jakovljevic, 2020). A su vez, la aplicación de Trichoderma spp. puede aumentar la eficiencia de la captura de nutrientes lo que favorece al crecimiento de la planta y brindar protección contra patógenos.
CONCLUSIONES
En este estudio, los hongos Trichoderma viride y T. harzianum presentaron un efecto antagónico significativo contra el crecimiento in vitro de P. cinnamomi causante de la marchitez radicular en plantaciones de aguacate de los Montes de María. Estas dos especies presentan diversos mecanismos para el control de patógenos, lo que las convierte en alternativas biológicas para el manejo y control de enfermedades en cultivos de interés económico. Además, por su rápido crecimiento pueden ser bioaumentadas en sustrato de arroz precocido para luego ser aplicados como bioproductos a cultivos de aguacate que se encuentran afectados por la enfermedad.